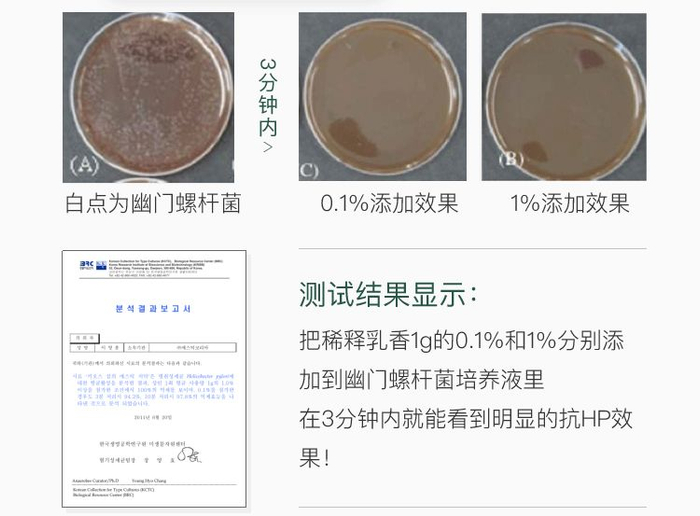

原标题:用对了牙膏,省下的钱令人咋舌
如果你经常生冷不忌、爱吃辣爱撸串,那么溃疡、口臭、牙周炎、甚至胃病早晚都会找上门……
毕竟病从口入,你知道吗,一个成年人口腔里的有害细菌,高达2000亿个!
虽然大部分细菌,很多牙膏都可以抑制,但是有一种细菌,就藏在胃黏膜里,连胃酸都杀不掉!

▲关于幽门螺杆菌的报道
这个可怕细菌叫幽门螺杆菌,在「全球致癌物」排54名,据统计,67%~80%的胃溃疡、胃癌和95%的十二指肠溃疡都由它引起!

▲世界卫生组织国际癌症研究机构公布的《120种一类致癌物清单》之一。

▲幽门螺杆菌是一种微需氧菌,生长在胃和十二指肠粘膜里,引起粘膜炎症,破坏胃黏膜。诺贝尔医学奖得主发现,在胃部强酸环境下,只有它能够存活下来。
更可怕的是它非常容易传染,聚餐、共筷、亲吻都有可能中招!因为传染途径只有口腔,所以医生建议除去药物治疗外,一定要做好口腔预防。

这支获得无数权威认证的「麦斯特凯斯乳香牙膏」,作为市面上专门针对幽门螺杆菌研发的牙膏,对预防胃病很有帮助,强烈推荐大家试一试!

独家专利认证
千万用户用了都说好
它刚面世就在2008年首尔国际发明展会上摘得银奖。还获得了韩国专利厅的认证。

▲ 左:获奖证明。右:专利证书(登记号码10-0795434)。
对日常出现的腹胀、打嗝、食欲不振现象也很有帮助,几乎是每个韩国家庭必备的牙膏,在各大购物网站上也是好评如潮!


不少人表示用过后每天口气清新,牙齿也慢慢白很多。

采用希腊顶级天然乳香
有效抑制幽门螺杆菌,癌症专家推荐它
为什么它如此有效呢?原因来自那2%希腊乳香成分。

说起杀菌,大部分人都不知道乳香杀菌效果是蜂胶的15.6倍,一切口腔细菌都难逃它的抵抗。


十大癌症专家巴巴拉博士,一直极力推崇乳香替代抗生素杀灭幽门螺杆菌。
▲点这里看博士深度解析乳香。

▲ 乳香,是从乳香黄连木中采取的树胶提取物。比起容易过敏和产生副作用的抗生素,它更加天然不刺激。
然而,乳香不是哪都有,谁都能用的。这支牙膏采用的是欧盟原产地保护(PDO)的认证的顶级天然乳香,没有证明都是假的。

▲ 欧洲原产地(PDO)的认证。
关于乳香,不只巴巴拉博士,许多研究院都做了多项实验,进一步证明它的功效。
▲ 韩国生命工程研究院实验报告


有了它,只需刷牙的功夫,就提前将细菌杀死在口腔,不用等到胃疼的去医院,不知省下多少医药费。

祛口臭,清除牙菌斑,护牙龈
这一支,抵很多支
不只是预防胃病,幽门螺杆菌引起的口臭以及各种牙龈问题它都能解决!

打开盖子发现膏体呈透明状,只需一点点,泡沫就很丰富。在刷牙的过程中能感觉到口腔每个角落都被清洗的很干净,刷完后口臭痕迹全无,嘴里留有淡淡的青草香。

每天早晚各刷3分钟,不仅肠胃好了些,意外的发现牙齿越来越白了,而且之前隔三差五牙龈出血、牙龈肿痛的毛病也痊愈了!

▲ 加入的羟磷灰石(HAP)粒子在去除牙菌斑时,修复牙齿黏膜损伤。
一查才知道,原来这支牙膏所适用的人不仅仅是肠胃不适,口腔问题、以及幽门螺杆菌引发的其他症状都能用!几十块钱就能预防这么多病症,也太划算了吧!

▲ 第四次全国幽门螺杆菌感染处理共识会推荐以下人士尤其需要做好抗HP工作。
俗话说花小钱,防大病,无论是自用还是买给家人,这支牙膏都是不错的选择!



